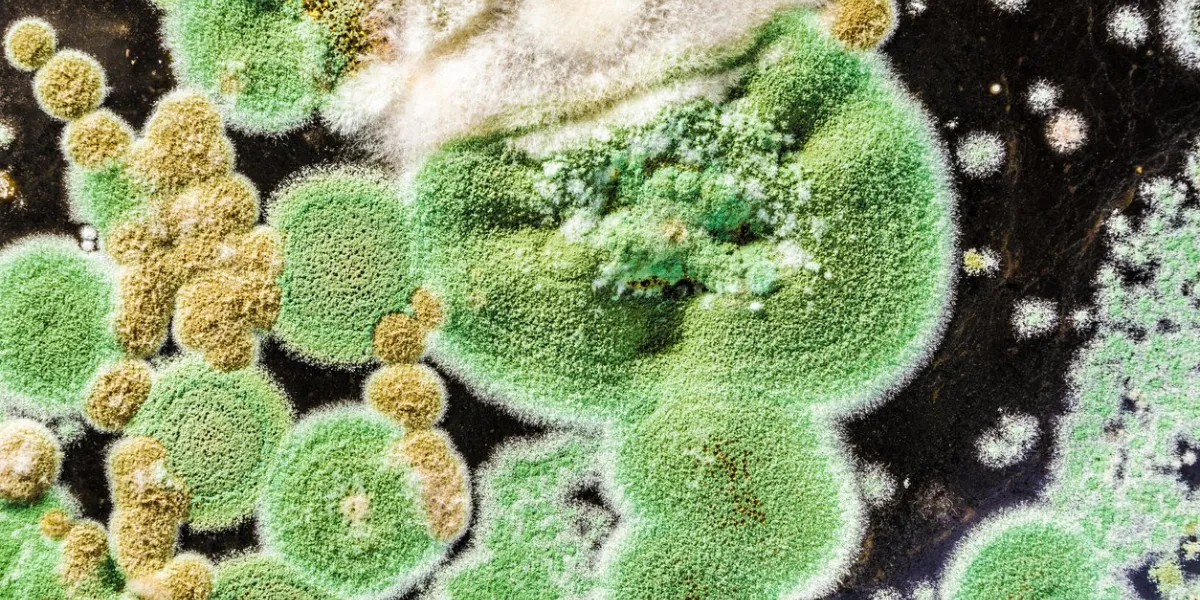

Réchauffement climatique : ces champignons mortels tuent des patients
De nouvelles infections fongiques pourraient bientôt menacer l’humanité d'après une nouvelle étude américaine. L’augmentation de la température favoriserait la prolifération et la résistance de champignons susceptibles de nuire à la santé de l’homme.
Des champignons mortels qui prolifèrent à cause de la chaleur
Habituellement, "les humains sont résistants aux infections fongiques car les champignons ne se développent pas bien avec la chaleur”, affirme le Dr Arturo Casadevall, auteur principal de l’étude.
Sauf que le réchauffement climatique bouleverse beaucoup de choses : il habitue ces pathogènes fongiques à des températures plus élevées, ce qui les rend plus résistants à la chaleur. Résultat, ils sont plus susceptibles d'infecter les humains.
En 2009, c’est la première fois qu’un champignon de type mortel (C.auris) est déclaré chez l’homme.
Ces souches ont même infecté des malades sur trois continents simultanément : au Venezuela, en Afrique du Sud et en Inde. Le problème ? Malgré le fait que les climats soient tous différents, le constat est le même : les champignons prolifèrent.
Les chercheurs en ont donc conclu que le champignon C. auris s'est adapté à toutes les conditions climatiques, ce qui pose un problème pour la santé de l'homme.
"95 % des germes fongiques ne supportent pas bien la chaleur normalement. Or, depuis leur évolution, ils prospèrent dans les milieux chauds mais aussi dans notre corps, qui possède une température élevée”, précise le Dr Arturo Casadevall.
Dans 30 % des cas, ils tuent les patients en s’attaquant à leurs organes
Selon les chercheurs, "plus de 30 % des personnes atteintes d’infections invasives au champignon C.auris décèdent."
685 cas de décès ont même été confirmés aux États-Unis depuis 2016.
Les chercheurs s’avouent "inquiets" face à la prolifération des infections fongiques :"ces champignons ont tendance à attaquer tout l’organisme et ils peuvent être très menaçants s’ils ne sont pas traités. Quand ils vous tuent, c'est parce qu'ils pénètrent à l'intérieur du corps et qu'ils endommagent vos organes internes", alerte le Dr Casadevall.
Jusqu'à présent, le champignon C. auris aurait principalement atteint les personnes malades dans les hôpitaux qui ont un système immunitaire plus faible.
"La mauvaise nouvelle c'est qu'une fois que ces champignons sont installés dans les hôpitaux et les maisons de retraite, ils sont extrêmement difficiles à éradiquer, voire impossibles", a déclaré le docteur. "Cet organisme, pour des raisons inconnues, semble être assez résistant."
Dans les années à venir, les experts en santé publique vont intensifier leurs efforts de surveillance en matière d'infections fongiques et essayer de trouver de nouveaux traitements afin d'éradiquer les champignons résistants.
Comment se protéger des champignons ?
Les infections fongiques sont courantes et assez difficiles à traiter. Le meilleur moyen de les combattre reste la prévention, aussi, voici quelques gestes simples à adopter au quotidien :
- Se laver les mains.
- Éviter les endroits publics (dans la mesure du possible).
- Porter des chaussures en toute circonstance (vestiaire, piscine publique, salle de sport...).
- Prévenir son employeur en cas d'infection fongique.
- Utiliser ses biens personnels (chaussures, chaussettes, produits de beauté…).
- Couvrir la partie de son corps infectée par un champignon.
- Changer ses draps régulièrement.
- Changer de sous-vêtements tous les jours.
- Prendre soin de ses pieds (Une poudre antifongique ou du talc peuvent être utilisés pour prévenir la transpiration et garder les pieds secs.)
- Prendre soin de ses ongles.
- Avoir une bonne hygiène générale.
Afficher les sources de cet article
"Climate Change Blamed for Deadly Fungus Risk", WebMD, 24 juillet 2019.
Johns Hopkins Center for Health Security, Baltimore, July/August 2019, mBio.